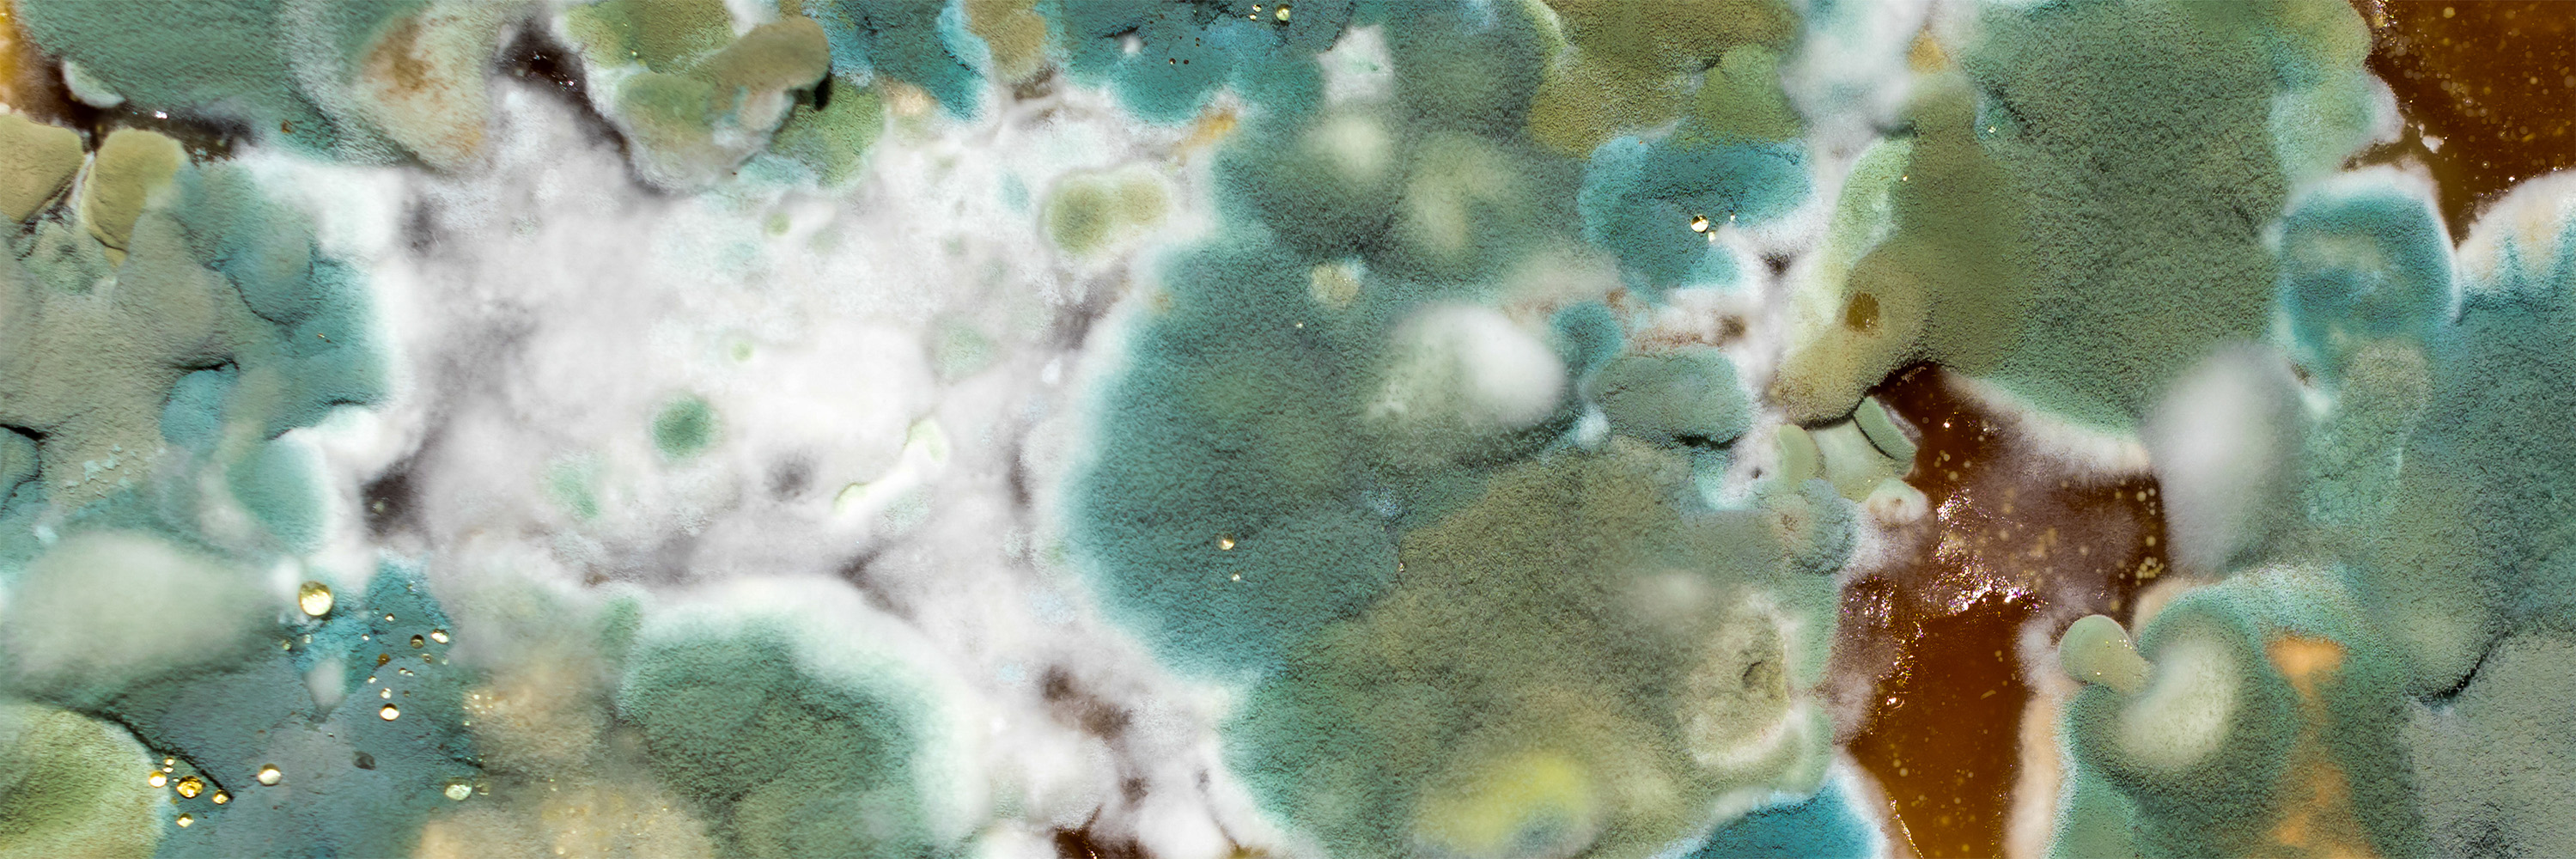

- INFO POINT
- Di Aurelio Coppi
VOC, radon e muffe: rischi, tecnologie e pratiche concrete per misurare, prevenire e correggere l’aria indoor.
La qualità dell’aria indoor è oggi una priorità sanitaria: trascorriamo fino al 90% del tempo in ambienti chiusi e molte fonti d’inquinamento domestico agiscono silenziose e cumulative. Composti organici volatili (VOC) derivanti da vernici, detergenti e mobili, radon geogenico che si accumula negli interrati, e spore di muffe legate a umidità e infiltrazioni costituiscono i tre profili principali di rischio.
Gli effetti spaziano da irritazioni acute a esiti cronici quali asma, malattie respiratorie e, nel caso del radon, aumentato rischio oncologico polmonare. Il quadro non è solo sanitario: incide su produttività, benessere psicofisico e costi energetici, perché molte misure di controllo richiedono gestione integrata di ventilazione e isolamento termico.
In questo articolo forniamo una panoramica tecnica ma pratica: come identificare le sorgenti, quali strumenti diagnostici scegliere, e quali interventi tecnologici e comportamentali applicare per ridurre esposizioni e migliorare la qualità dell’aria in abitazioni, scuole e uffici.



VOC: fonti, effetti e strategie di riduzione
I VOC coprono centinaia di composti (formaldeide, toluene, benzene, acetaldeide) con origine in materiali da costruzione, arredamento, prodotti per la pulizia e combustione incompleta. A basse concentrazioni provocano irritazione o cefalea; esposizioni prolungate possono implicare effetti neurologici e cancerogenicità in alcuni casi.
Una loro corretta misurazione è la base da cui partire: sensori elettronici a fotoionizzazione (PID) forniscono indicazioni rapide su concentrazioni totali, mentre analisi in laboratorio (GC-MS) identificano singoli composti quando necessario.
Sul piano tecnico, la prima leva è agire sulla sorgente: scegliere materiali a basse emissioni (classi E1, marchi ecologici), limitare l'uso di solventi volatili e preferire detergenti a basso impatto. La ventilazione meccanica controllata (VMC) con recupero di calore, opportunamente dimensionata e dotata di filtri di classe F7/HEPA dove richiesto, riduce carichi VOC senza penalizzare l’efficienza energetica.
Gestione e tecnologie per il controllo dei VOC negli ambienti interni
Trattamenti addizionali quali filtri a carboni attivi o unità di purificazione con adsorbenti specifici sono efficaci per VOC persistenti; tuttavia richiedono manutenzione programmata e monitoraggio dei climi interni per evitare rilascio secondario. Infine, un programma di gestione operativa — aerazione dopo operazioni di verniciatura, tempi di stagionatura mobili, controllo dei prodotti utilizzati — è cruciale e spesso più efficace e meno costoso di interventi tecnici complessi.


Radon: misurazione, normative e mitigazione tecnica
Il radon è un gas nobile radioattivo generato dal decadimento dell’uranio nel sottosuolo; la sua concentrazione varia fortemente per geologia e caratteristiche edilizie. È il principale fattore ambientale di rischio per il cancro polmonare dopo il fumo.
La diagnosi richiede misure affidabili: dosimetri passivi a lunga durata (2–12 mesi) per valutazioni conformi alle linee guida, o monitor multiparametro per screening rapido. In Italia le normative regionali e le raccomandazioni ISPRA/ISS definiscono limiti di riferimento e criteri di intervento: concentrazioni significativamente sopra 300 Bq/m3 impongono azioni correttive.
Le tecniche di mitigazione comprendono sistemi di depressurizzazione della sottosoletta, ventilazione forzata dei locali interrati e impermeabilizzazione delle superfici di contatto col suolo. L’efficacia è verificabile solo con monitoraggi post-intervento. Dal punto di vista costi-benefici, le soluzioni più diffuse (depressurizzazione attiva) sono relativamente economiche e risolvono la maggioranza dei casi domestici; nelle nuove costruzioni è essenziale prevedere barriere al flusso d’aria dal suolo e predisporre tubazioni di ventilazione radon-proof nella fase progettuale. Informazione pubblica e screening mirati in aree geologiche a rischio restano comunque passaggi imprescindibili (e non sempre seguiti da chi ne avrebbe la responsabilità) per ridurre l’esposizione a livello di popolazione.



Muffe e umidità: prevenzione edilizia e rimedi pratici
La crescita di muffe è segnale di squilibri igrotermici: infiltrazioni, ponti termici, ventilazione insufficiente e microclimi interni favoriscono proliferazione e rilascio di spore e micotossine. Le conseguenze includono reazioni allergiche, peggioramento di asma e sindromi da esposizione indoor.
La diagnosi tecnica combina ispezione visiva, misurazioni di umidità (igrometri, termocamere per individuare ponti termici) e, quando necessario, analisi microbiologiche per identificare specie e carico spore.
Interventi prioritari sono, ovviamente, la rimozione delle cause: riparazione di perdite, correzione dei ponti termici, adeguata stratigrafia delle pareti e controllo dell’umidità interna mediante ventilazione.
In edifici esistenti, deumidificatori elettrici e VMC con recuperatore possono stabilizzare i livelli igrometrici; in ambienti con danni estesi è necessaria una bonifica professionale che prevede contenimento, rimozione e trattamento dei materiali contaminati.
Strategie preventive per la gestione dell’umidità
Buone pratiche d’uso — mantenere umidità relativa tra 40–60%, garantire ricambio d’aria quotidiano, asciugare in modo corretto biancheria e evitare accumuli di polvere organica — sono efficaci e a basso costo. Per edifici sensibili (scuole, asili, strutture sanitarie) sono raccomandabili programmi di manutenzione preventiva, monitoraggio continuo e formazione del personale per riconoscere e intervenire tempestivamente sui segnali di degrado.
La soluzione? Sempre un approccio integrato
La gestione della qualità dell’aria indoor richiede un approccio integrato: identificazione puntuale delle sorgenti, monitoraggio adeguato e combinazione di soluzioni edilizie, tecnologiche e comportamentali. Strumenti di ventilazione efficiente, filtri selettivi, misurazioni qualificate e interventi edilizi mirati rappresentano un set operativo che, se applicato coerentemente, riduce esposizioni e migliora salute e comfort. La redazione di Bolab.it continuerà a seguire aggiornamenti normativi e tecnologie emergenti per supportare professionisti e decisori nelle scelte operative.